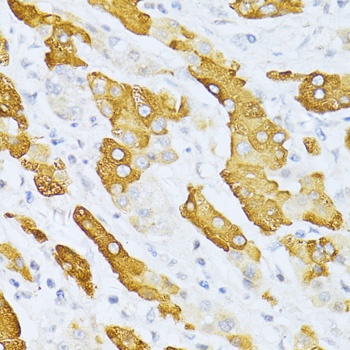
Product Image

Description
CYP2E1 Antibody (CAB2160)
The CYP2E1 Antibody (CAB2160) is a high-quality antibody developed for reliable detection and analysis of target proteins. Raised in rabbits, this antibody offers high reactivity with human samples and is validated for use in Western blot applications. By specifically binding to the Cytochrome P450 2E1 protein, researchers can easily detect and analyze its expression in various cell types, making it ideal for studies in pharmacology and toxicology.Cytochrome P450 2E1 is known for its role in metabolizing a wide range of chemical compounds, including environmental toxins and commonly used medications.
This antibody is validated for use in WB, IHC-P, ELISA, IF-P applications and has demonstrated reactivity against Human, Mouse, Rat samples.
| Product Name: | CYP2E1 Antibody |
| SKU: | CAB2160 |
| Size: | 20μL, 100μL |
| Reactivity: | Human, Mouse, Rat |
| Conjugate: | Unconjugated |
| Immunogen: | Recombinant protein (or fragment).This information is considered to be commercially sensitive. | ||||||||
| Sequence: | KVIK NVAE VKEY VSER VKEH HQSL DPNC PRDL TDCL LVEM EKEK HSAE RLYT MDGI TVTV ADLF FAGT ETTS TTLR YGLL ILMK YPEI EEKL HEEI DRVI GPSR IPAI KDRQ EMPY MDAV VHEI QRFI TLVP SNLP HEAT RDTI FRGY LIPK GTVV VPTL DSVL YDNQ EFPD PEKF KPEH FLNE NGKF KYSD YFKP FSTG KRVC AGEG LARM ELFL LLCA ILQH FNLK PLVD PKDI DLSP IHIG FGCI PPRY KLCV IPRS | ||||||||
| Tested Applications: | WB IHC-P ELISA IF-P | ||||||||
| Recommended Dilution: |
| ||||||||
| Synonyms: | CPE1, CYP2E, P450-J, P450C2E, CYP2E1 |
| Positive Sample: | Rat liver |
| Cellular Localization: | Endoplasmic Reticulum Membrane, Microsome Membrane, Peripheral Membrane Protein. |
| Calculated MW: | 57kDa |
| Observed MW: | 55kDa |
This gene encodes a member of the cytochrome P450 superfamily of enzymes. The cytochrome P450 proteins are monooxygenases which catalyze many reactions involved in drug metabolism and synthesis of cholesterol, steroids and other lipids. This protein localizes to the endoplasmic reticulum and is induced by ethanol, the diabetic state, and starvation. The enzyme metabolizes both endogenous substrates, such as ethanol, acetone, and acetal, as well as exogenous substrates including benzene, carbon tetrachloride, ethylene glycol, and nitrosamines which are premutagens found in cigarette smoke. Due to its many substrates, this enzyme may be involved in such varied processes as gluconeogenesis, hepatic cirrhosis, diabetes, and cancer.
| Purification Method | Affinity purification |
| Gene ID | 1571 |
| RRID | AB_2764178 |
| Buffer Information | Store at -20℃. Avoid freeze / thaw cycles. Buffer: PBS containing 50% glycerol, preserved with proclin300 or sodium azide, pH 7.3. |